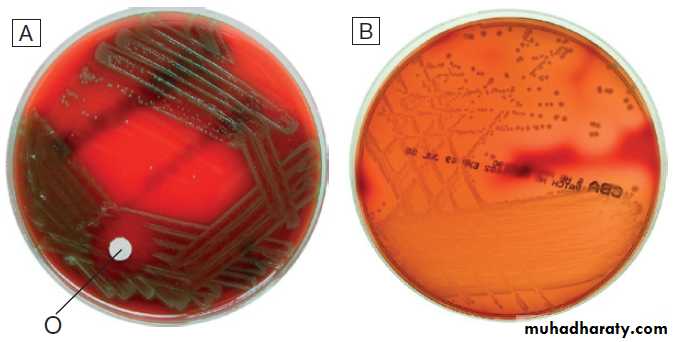
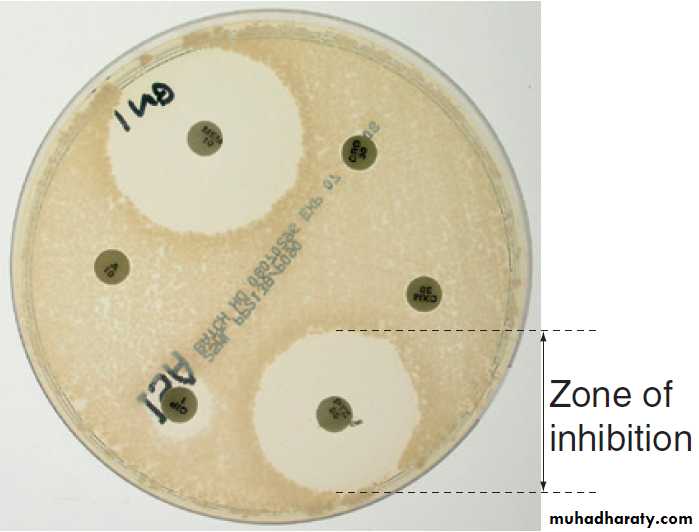

Hussien Mohammed Jumaah
CABMLecturer in internal medicine
Mosul College of Medicine
2016
learning-topics
Principles of infectious diseaseInfection is the establishment of foreign organisms, or
‘infectious agents’, in or on a human host. This mayresult in colonisation, if the microorganism exists at
an anatomical site without causing harm, or infectious
disease, when the interaction between the host and
microorganism (pathogen) results in illness. In clinical
practice, the term ‘infection’ is often used interchangeably
with ‘infectious disease’. Most pathogens are microorganisms, although some are multicellular organisms. The host–pathogen interaction is dynamic and
complex. Whilst it is rarely in the microorganism’s interest to kill the host (on which it relies for nutrition and
protection), the manifestations of disease may aid its
dissemination (e.g. diarrhoea, sneezing).
Conversely, it is in the host’s interests to kill microorganisms likely to cause disease, whilst preserving colonising organisms, which may be beneficial.
Communicable diseases are caused by organisms
transmitted between hosts, whereas endogenous diseases
are caused by organisms already colonising the
host. Cross-infection with colonising organisms (e.g.
meticillin-resistant Staphylococcus aureus, MRSA) is both
communicable and endogenous. Opportunistic infections
may be communicable or endogenous and arise
only in individuals with impaired host defence.
The chain of infection describes six essential elements for communicable disease transmission.
Despite dramatic advances in hygiene, immunisation
and antimicrobial therapy, infectious diseases are still a major cause of disease worldwide. Key challenges
remain in tackling infection in resource-poor countries
and in the emergence of new infectious agents and
antimicrobial-resistant microorganisms. This chapter
describes the biological and epidemiological principles
of infectious diseases and the general approach to their
prevention, diagnosis and treatment.
Chain of infection. The infectious agent is the organism that
causes the disease. The reservoir is the place where the population of an infectious agent is maintained. The portal of exit is the point from which the infectious agent leaves the reservoir. Transmission is the process by which the infectious agent is transferred from the reservoir to the humanhost, either directly or via a vector or fomite. The portal of entry is the body site that is first accessed by the infectious agent. Finally, in order for disease to ensue, the person to whom the infectious agent is transmitted must be a susceptible host.
INFECTIOUS AGENTS
The concept of an infectious agent was established byRobert Koch in the 19th century (Box). Although
fulfilment of ‘Koch’s postulates’ became the standard for
the definition of an infectious agent, they do not apply
to uncultivable organisms (e.g. Mycobacterium leprae,
Tropheryma whipplei) or members of the normal human
flora (e.g. Escherichia coli, Candida spp.).
Definition of an infectious agent – Koch’s postulates
The following groups of infectious agents are now recognised.Prions
Prions are unique amongst infectious agents in that they
are devoid of any nucleic acid. They appear to be transmitted by acquisition of a normal mammalian protein
(prion protein, PrPC) which is in an abnormal conformation
(PrPSC, containing an excess of beta-sheet protein);
the abnormal protein inhibits the 26S proteasome, which
can degrade misfolded proteins, leading to accumulation
of the abnormally configured PrPSC protein instead
of normal PrPC. The result is accumulation of protein
which forms amyloid in the central ne rvous system,
causing a transmissible spongiform encephalopathy.
Viruses
Viruses are incapable of independent replication, instead
subverting host cellular processes to ensure synthesis of
their nucleic acids and proteins. A virus that infects a
bacterium is a bacteriophage (phage). Viruses contain
genetic material (genome), which may be single- or
double-stranded DNA or RNA.
Retroviruses transcribe their RNA into DNA by reverse transcription.
An antigenically unique protein coat (capsid) encloses the genome, together forming the nucleocapsid.
In many viruses, the nucleocapsid is packaged within a lipid
envelope.
Enveloped viruses are less able to survive in
the environment and are spread by respiratory, sexualor blood-borne routes, including arthropod-based transmission.
Non-enveloped viruses survive better in
the environment and are predominantly transmitted by
faecal–oral or, less often, respiratory routes.
Fig. A generic virus life cycle. Life cycle components common to most viruses are host cell attachment and penetration, virus uncoating, nucleic acid and protein synthesis, virus assembly and release. Virus release is achieved either by budding, as illustrated, or by lysis of the cell membrane. Life cycles vary between viruses.
Prokaryotes: bacteria (including mycobacteria and actinomycetes)
Prokaryotic cells are capable of synthesising their ownproteins and nucleic acids, and are able to reproduce
autonomously, although they lack a nucleus. The bacterial
cell membrane is bounded by a peptidoglycan cell
wall, which is thick (20–80 nm) in Gram-positive organisms
and thin (5–10 nm) in Gram-negative ones. The
Gram-negative cell wall is surrounded by an outer membrane containing lipopolysaccharide. Plasmids are rings of extra-chromosomal DNA within bacteria, which can
be transferred between organisms.
Bacteria may be embedded in a polysaccharide capsule, and motile bacteria are equipped with flagella.
Although many prokaryotes are capable of independent existence, some (e.g. Chlamydia trachomatis, Coxiella burnetii) are obligate intracellular organisms.
Bacteria that replicate in artificial culture media are classified and identified using a range of characteristics (Box), with examples in Figures
How bacteria are identified
Gram stain reaction• Gram-positive (thick peptidoglycan layer), Gram-negative (thin peptidoglycan) or unstainable
Microscopic morphology
• Cocci (round cells) or bacilli (elongated cells)
• Presence or absence of capsule
Cell association
• Associated in clusters, chains or pairs
Colonial characteristics
• Colony size, shape or colour
• Effect on culture media (e.g. β-haemolysis of blood agar inhaemolytic streptococci
How bacteria are identified– cont’d
Gram film appearances of bacteria on light microscopy (×100).
Appearances of α- and β-haemolytic streptococci on blood agar.
A Alpha-haemolytic streptococci. The colonies cause partial haemolysis, which imparts a green tinge to the agar. The organism shown is Strep. pneumoniae from the cerebrospinal fluid of a patient with meningitis (note also the susceptibility to optochin (O), which is another feature used to identify this organism).B Beta-haemolytic streptococci. The colonies cause complete haemolysis, which renders the agar transparent. The organism shown is Strep. pyogenes (group A
β-haemolytic streptococci) from a superficial wound swab.
Eukaryotes: fungi, protozoa and helminths
Eukaryotes contain functional organelles, includingnuclei, mitochondria and Golgi apparatus. Eukaryotes
involved in human infection include fungi, protozoa
(unicellular eukaryotes with a flexible cell membrane ),
and helminths (complex multicellular organisms
including nematodes, trematodes and cestodes).
Fungi exist as either moulds (filamentous fungi) or
yeasts. Dimorphic fungi exist in either form, depending
on environmental conditions . The fungal plasma membrane differs from the human cell membrane in that it contains the sterol, ergosterol. Fungi have a cell wall made up of polysaccharides, chitin and manno-proteins. Protozoa and helminths are often referred to as parasites.
NORMAL FLORA
Every human is host to an estimated 1013–1014 colonising
microorganisms, which constitute the normal flora. Resident
flora are able to survive and replicate at a body site,
whereas transient flora are present only for short periods. Knowledge of non-sterile body sites and their normal
flora is required to interpret culture results (Fig.).
The relationship between human host and normal
flora is symbiotic, meaning that the organisms are in
close proximity, and either mutualistic (both organisms
benefit) or commensal (one organism benefits whilst the
other derives neither benefit nor harm).
The microbiome is the total burden of microorganisms, their genes and environmental interactions; the human microbiome is recognised increasingly as exerting a profound influence over human health and disease.
Maintenance of the normal flora is beneficial to
health. For example, lower gastrointestinal tract bacteria
synthesise and excrete vitamins (e.g. vitamins K and B12);
colonisation with normal flora confers ‘colonisation
resistance’ to infection with pathogenic organisms by
altering the local environment (e.g. lowering pH), producing antibacterial agents (e.g. bacteriocins, fatty acids and metabolic waste products), and inducing host antibodies which cross-react with pathogenic organisms.
Conversely, normally sterile body sites must be kept
sterile. The mucociliary escalator transports environmentalmaterial deposited in the respiratory tract to the
nasopharynx.
The urethral sphincter prevents flow from the non-sterile urethra to the sterile bladder. Physical barriers, including the skin, lining of the gastrointestinal tract and mucous membranes, maintain sterility of the blood stream, peritoneal and pleural cavities, chambers of the eye, subcutaneous tissue and so on.
The normal flora contribute to endogenous disease by
either excessive growth at the ‘normal’ site (overgrowth)
or translocation to a sterile site.
Overgrowth is exemplified by ‘blind loop’ syndrome , dental caries and vaginal thrush, in which external factors favour overgrowth of specific components of the normal flora. Translocation results from spread along a surface or
penetration of a closed barrier: for example, in urinary
tract infection caused by perineal/enteric flora, and in
surgical site infections, particularly of prosthetic materials,
caused by skin flora such as staphylococci.
Normal flora also contribute to disease by cross-infection, in which organisms that are colonising one individual cause disease when transferred to another, more susceptible, individual.
Human non-sterile sites and normal flora in health.
HOST–PATHOGEN INTERACTIONSPathogenicity is the capability of an organism to
cause disease and virulence is the extent to which
a pathogen is able to cause disease. Pathogens produce proteins and other factors, termed virulence factors,
which interact with host cells to contribute to disease.
• Primary pathogens cause disease in a proportion of
individuals to whom they are exposed, regardless
of their immunological status.
• Opportunistic pathogens cause disease only in
individuals whose host defences are compromised;
for example, by genetic susceptibility or
immunosuppressive disease or therapy.
Characteristics of successful pathogens
Successful pathogens have a number of attributes. They
compete with host cells and colonising flora by various
methods, including sequestration of nutrients, use of
metabolic pathways not used by competing bacteria,
and production of bacteriocins (small antimicrobial
peptides/proteins that kill closely related bacteria).
Motility enables pathogens to reach their site of infection,
often in sterile sites that colonising bacteria do not
reach, such as the distal airway.
Many microorganisms, including viruses, use ‘adhesins’ to attach to host cells at the site of infection.
Other pathogens can invade through tissues.
Pathogens may produce toxins, microbial molecules that cause adverse effects on host cells, either at the site of infection, or remotely following carriage through the blood stream. Endotoxin is the lipid A domain of Gram-negative bacterial outer membrane lipopolysaccharide. It is released when bacterial cells are damaged and has generalised inflammatory effects. Exotoxins are proteins released by living bacteria, which often have specific effects on target organs . Intracellular pathogens, including viruses, bacteria (e.g. Salmonella spp., Listeria monocytogenes and Mycobacterium tuberculosis), parasites (e.g. Leishmania spp.) and fungi (e.g. Histoplasma capsulatum), are able to survive in intracellular environments, including after phagocytosis
by macrophages.
Pathogenic bacteria express different arrays of genes,
depending on environmental stress (pH, iron starvation,O2 starvation and so on) and anatomical location. In
quorum sensing, bacteria communicate with one another
to adapt their replication or metabolism according to
local population density. Bacteria and fungi may respond
to the presence of an artificial surface (e.g. prosthetic
device, venous catheter) by forming a biofilm, which is
a population of organisms encased in a matrix of extracellular molecules. Biofilm-associated organisms are
highly resistant to antimicrobial agents. Genetic diversity enhances the pathogenic capacity of bacteria.
Some virulence factor genes are found on plasmids
or in phages and are exchanged between different
strains or species. The ability to acquire genes from the
gene pool of all strains of the species (the ‘bacterial
supragenome’) increases diversity and the potential for
pathogenicity. Viruses exploit their rapid reproduction
and potential to exchange nucleic acid with host cells to
enhance diversity. Once a strain acquires a particularly
effective combination of virulence genes, it may become
an epidemic strain, accounting for a large subset of infections in a particular region.
This phenomenon accounts for influenza pandemics.
Exotoxin-mediated bacterial disease
Antibiotic-associated diarrhoea/pseudomembranous colitisClostridium difficile
Botulism Clostridium botulinum
Cholera Vibrio cholerae
Diphtheria Corynebacterium diphtheriae
Haemolytic uraemic syndrome
Escherichia coli O157 (and other strains)
Necrotising pneumonia
Staphylococcus aureus
Tetanus Clostridium tetani
Toxic shock syndrome Staphylococcus aureus
The host response
Innate and adaptive immune and inflammatory
responses which humans use to control the normal flora
and respond to pathogens was reviewed.
Pathogenesis of infectious disease
The harmful manifestations of infection are determined
by a combination of the virulence factors of the organism
and the host response to infection. Despite the
obvious benefits of an intact host response, an excessive
response is undesirable. Cytokines and antimicrobial
factors contribute to tissue injury at the site of infection,
and an excessive inflammatory response may lead to
hypotension and organ dysfunction .
The contribution of the immune response to disease manifestations is exemplified by the immune reconstitution
inflammatory syndrome (IRIS). This is seen, for example,
in human immunodeficiency virus (HIV) infection,
post-transplantation neutropenia or tuberculosis (which
causes suppression of T-cell function): there is a paradoxical worsening of the clinical condition as the
immune dysfunction is corrected, caused by an exuberant
but dysregulated inflammatory response.
The febrile response
Thermoregulation is altered in infectious disease.
Microbial pyrogens or the endogenous pyrogens
released during tissue necrosis stimulate specialised
cells such as monocytes/macrophages to release
cytokines, including interleukin (IL)-lβ, tumour necrosis
factor-alpha (TNF)-α, IL-6 and interferon (IFN)-γ.
Cytokine receptors in the pre-optic region of the anterior
hypothalamus activate phospholipase A, releasing arachidonic acid as substrate for the cyclo-oxygenase
pathway and producing prostaglandin E2 (PGE2), which
in turn alters the responsiveness of thermosensitive
neurons in the thermoregulatory centre.
Rigors occur when the body inappropriately attempts to ‘reset’ core temperature to a higher level by stimulating skeletal muscle activity and shaking.
The role of the febrile response as a defence mechanism
requires further study, but there are data to support
the hypothesis that raised body temperature interferes
with the replication and/or virulence of pathogens.
INVESTIGATION OF INFECTION
Include non-specific tests that reflect innate immune and acute phase responses and specific tests, which detect either a microorganism or the host response to the organism (Box).Careful sampling increases the likelihood of diagnosis (Box). Culture results must be interpreted in thecontext of the normal flora at the sampled site .The extent to which a microbiological test result supports or excludes a particular diagnosis depends on its statistical performance (e.g. sensitivity, specificity, positive and negative predictive value). Sensitivity and specificity vary according to the time between infection and testing, and positive and negative predictive values depend on the prevalence of the condition in the test population.
Tests used to diagnose infection
How to provide samples for microbiological sampling
How to provide samples for
microbiological sampling – cont’dDirect detection
Direct detection methods provide rapid results and maybe applied to organisms that cannot be grown easily on
artificial culture media, such as Chlamydia spp. They do
not usually provide information on antimicrobial susceptibility or the degree to which organisms are related
to each other (which is important in the investigation
of possible outbreaks), unless relevant specific nucleic
acid sequences are detected by polymerase chain
reaction (PCR).
Detection of whole organisms
Whole organisms are detected by examination of biological fluids or tissue using a microscope.
• Bright field microscopy (in which the test sample is
interposed between the light source and the
objective lens) uses stains to enhance visual contrast
between the organism and its background. Examples include Gram staining of bacteria and Ziehl–Neelsen or auramine staining of acid- and alcohol-fast bacilli (AAFB) in tuberculosis.
In histopathological examination of tissue samples, multiple stains are used to demonstrate not only the presence of microorganisms, but also features of disease pathology.
• Dark field microscopy (in which light is scattered to
make organisms appear bright on a darkbackground) is used, for example, to examine
genital chancre fluid in suspected syphilis.
• Electron microscopy may be used to examine stool
and vesicle fluid to detect enteric and herpesviruses,
respectively, but its use has largely been supplanted
by nucleic acid detection (see below).
Detection of components of organisms
Components of microorganisms detected for diagnosticpurposes include nucleic acids, cell wall molecules,
toxins and other antigens. Commonly used examples
include Legionella pneumophila serogroup 1 antigen in
urine and cryptococcal polysaccharide antigen in cerebrospinal fluid (CSF). Most antigen detection methods are based on in vitro binding of specific antigen/ antibody and are described below . However, other methods may be used, such as mouse bioassay for detection of Clostridium botulinum toxin or tissue culture cytotoxicity assay for C. difficile toxin. In toxin-mediated disease, detection of toxin may be of greater relevance than identification of the organism itself (e.g. stool C. difficile toxin).
Nucleic acid amplification tests (NAAT)
Specific sequences of microbial DNA and RNA are identified using a nucleic acid primer which is amplified
exponentially by enzymes to generate multiple copies
of the specific sequence. The most commonly used
amplification method is the polymerase chain reaction
(PCR). Reverse transcription (RT) PCR is used to detect RNA from RNA viruses (e.g. hepatitis C virus and HIV-1). The use of fluorescent-labelled primers and probes enables ‘real-time’ detection of amplified DNA. Nucleic acid sequencing is also used to assign microorganisms to specific strains according to their genotype, which may be relevant to treatment and/or prognosis (e.g. in hepatitis C infection).
Genes that are relevant to pathogenicity (such as toxin genes) or antimicrobial resistance can also be detected. For
example, detection of the mecA gene is used to screen
for MRSA. NAAT are the most sensitive direct detection methods and are particularly useful when a rapid diagnosis is required.
They are used widely in virology, where the
possibility of false-positive results from colonising or
contaminating organisms is remote, and are applied
to blood, respiratory samples, stool and urine. In
bacteriology, PCR is used to examine CSF, blood, tissue
and genital samples, and multiplex PCR is being developed
for use in faeces. PCR is also being used increasingly
in mycology and parasitology.
Culture
Microorganisms may be both detected and further characterised by culture from clinical samples (e.g. tissue,swabs and body fluids).
• In vivo culture (in a living organism) is not used in
routine diagnostic microbiology.
• Ex vivo culture (tissue or cell culture) was widely
used in the isolation of viruses, but has been largely
supplanted by nucleic acid amplification techniques.
• In vitro culture (in artificial culture media) of bacteria
and fungi is used for definitive identification, to test for antimicrobial susceptibility and to subtype the organism for epidemiological purposes. However, culture has its limitations. Results are not immediate, even for organisms which are easy to grow, and negative culture rarely excludes infection completely. Organisms such as Mycobacterium tuberculosis are inherently slow-growing, typically taking at least 2 weeks to be detectable, even in specialised systems. Certain organisms, such as Mycobacterium leprae and Tropheryma whipplei, cannot be cultivated on artificial media, and others (e.g. Chlamydia spp. and viruses) grow only in ex vivo systems, which are slow and labour-intensive to use.
Blood culture
Rapid microbiological diagnosis is required for bloodstream infection (BSI). To diagnose BSI, a liquidculture medium is inoculated with freshly drawn blood,
transported to the microbiology laboratory and incubated
in a system that monitors it constantly for products
of microbial respiration (mainly CO2), generally
using fluorescence. If growth is detected, organisms are
identified and sensitivity testing is performed. Traditionally,
identification has been achieved by Gram stain
and culture.
However, MALDI-TOF (Box) is being used increasingly, as it is rapid and inexpensive, and enables identification of organisms directly from the blood-culture medium.
An overview of the processing of blood cultures. *In laboratories equipped with MALDI-TOF, rapid definitive organism
identification may be achieved at stage 6 and/or stage 8.
Specific immunological tests
Immunological tests may be used to detect the host
response to a specific microorganism, and can enable the
diagnosis of infection with organisms that are difficult
to detect by other methods or are no longer present in
the host.
The term ‘serology’ describes tests carried out
on serum, and is used to include both antigen and
antibody detection.
Antibody detection
Organism-specific antibody detection is applied mainlyto blood (Fig.). Results are typically expressed as
titres: that is, the reciprocal of the highest dilution of the
serum at which antibody is detectable (for example,
detection at serum dilution of 1 : 64 gives a titre of 64).
‘Seroconversion’ is defined as either a change from
negative to positive detection or a fourfold rise in titre
between acute and convalescent serum samples. An
acute sample is usually taken during the first week of
disease and the convalescent sample 2–4 weeks later.
Earlier diagnosis can be achieved by detection of IgM
antibodies, which are produced early in infection.
A limitation of these tests is that antibody production
requires a fully functional host immune system, so there
may be false-negative results in immunocompromised
patients. Also, other than in chronic infections and with
IgM detection, antibody tests usually provide a retrospective diagnosis.
Antibody detection methods are described below
(antigen detection methods are also described here as
they share similar methodology).
Detection of antigen, nucleic acid and antibody in infectious disease. The acute sample is usually taken during the first week of illness,
and the convalescent sample 2–4 weeks later. Detection limits and duration of detectability vary between tests and diseases, although in most diseases
immunoglobulin (Ig) M is detectable within the first 1–2 weeks.
Enzyme-linked immunosorbent assay
The principles of the enzyme-linked immunosorbentassay (ELISA, EIA) are illustrated in Figure. These
assays rely on linking an antibody with an enzyme
which generates a colour change on exposure to a
chromogenic substrate. Various configurations allow
detection of antigens or specific subclasses of immunoglobulin (e.g. IgG, IgM, IgA).
ELISA may also be adapted to detect PCR products, using immobilised oligonucleotide hybridisation probe and various detection systems.
Antibody (Ab) and antigen (Ag) detection by enzyme-linked immunosorbent assay (ELISA). This can be configured in various ways.
A Patient Ab binds to immobilised specific Ag, and is detected by addition of anti-immunoglobulin–enzyme conjugate and chromogenic substrate.
B Patient Ab binds to immobilised Ig subclass-specific Ab, and is detected by addition of specific Ag, followed by antibody–enzyme conjugate and chromogenic substrate.
C Patient Ab and antibody–enzyme conjugate bind to immobilised specific Ag. Magnitude of colour change reaction is inversely proportional to concentration of patient Ab.
D Patient Ag binds to immobilised Ab, and is detected by addition of antibody–enzyme conjugate and chromogenic substrate. In A, the conjugate Ab is specific for human immunoglobulin. In B–D, it is specific for Ag from the disease-causing organism.
Immunoblot (Western blot)
Microbial proteins are separated according to molecularweight by polyacrylamide gel electrophoresis
(PAGE) and transferred (blotted) on to a nitrocellulose
membrane, which is incubated with patient serum.
Binding of specific antibody is detected with an enzyme–anti-immunoglobulin conjugate similar to that
used in ELISA, and specificity is confirmed by its location
on the membrane. Immunoblotting is a highly
specific test, which may be used to confirm the results
of less specific tests such as ELISA.
Immunofluorescence assays
Immunofluorescence assays (IFAs) are highly specific.In indirect immunofluorescence, a serum sample is incubate
with immobilised antigen (e.g. cells known to be
infected with virus on a glass slide) and antibody
binding is detected using a fluorescent-labelled antihuman
immunoglobulin (the ‘secondary’ antibody). This method can also detect organisms in clinical samples (usually tissue or centrifuged cells) using a specific antibody in place of patient serum. In direct immunofluorescence, clinical samples are incubated directly with fluorescent-labelled specific antibodies to detect antigen, eliminating the need for secondary antibody.
Complement fixation test
In a complement fixation test (CFT), patient serum is
heat-treated to inactivate complement, and added to
specific antigen. Any specific antibody present in the
serum will complex with the antigen. Complement is
then added to the reaction. If antigen–antibody complexes
are present, the complement will be ‘fixed’
(consumed). Sheep erythrocytes, coated with an antierythrocyte antibody, are added. The degree of erythrocyte lysis reflects the remaining complement and is
inversely proportional to the level of the specific antigen–
antibody complexes.
Agglutination tests
When antigens are present on the surface of particles(e.g. cells, latex particles or microorganisms) and crosslinked with antibodies, visible clumping (or ‘agglutination’) occurs.
• In direct agglutination, patient serum is added to a
suspension of organisms that express the test
antigen. For example, in the Weil–Felix test, host
antibodies to various rickettsial species cause
agglutination of Proteus bacteria because they
cross-react with bacterial cell surface antigens.
• In indirect (passive) agglutination, specific antigen is
attached to the surface of carrier particles which
agglutinate when incubated with patient samples
that contain specific antibodies.
• In reverse passive agglutination (an antigen detection
test), the carrier particle is coated with antibody
rather than antigen.
Other tests
Immunodiffusion involves antibodies and antigenmigrating through gels, with or without the assistance
of electrophoresis, and forming insoluble complexes
where they meet. The complexes are seen on staining
as ‘precipitin bands’. Immunodiffusion is used in the
diagnosis of endemic mycoses and some forms
of aspergillosis . Immunochromatography is used to detect antigen. The system consists of a porous test strip (e.g. a nitrocellulose membrane), at one end of which there is
target-specific antibody, complexed with coloured
microparticles. Further specific antibody is immobilised
in a transverse narrow line some distance along the strip.
Test material (e.g. blood or urine) is added to the
antibody–particle complexes, which then migrate alongthe strip by capillary action. If these are complexed with
antigen, they will be immobilised by the specific antibody
and visualised as a transverse line across the strip.
If the test is negative, the antibody–particle complexes
will bind to a line of immobilised anti-immunoglobulin
antibody placed further along the strip, which acts as a
negative control. Immunochromatographic tests are
rapid and relatively cheap to perform, and are appropriate for point-of-care testing, e.g. in HIV 1.
Antibody-independent specific immunological tests
Interferon-gamma release assays (IGRA) are being used
increasingly to diagnose tuberculosis . The principle
of the assay is that T lymphocytes of patients
infected with Mycobacterium tuberculosis (MTB) release
IFN-γ when they are exposed to MTB-specific peptides.
The absence of these peptides in bacille Calmette–Guérin
(BCG) vaccine results in IGRA tests being more specific for the diagnosis of tuberculosis infection than the tuberculin skin test , because the latter may be positive as a result of previous BCG vaccination.
Antimicrobial susceptibility testing
If growth of microorganisms in culture is inhibited bythe addition of an antimicrobial agent, the organism is
considered to be susceptible. Bacteriostatic agents cause
reversible inhibition of growth and bactericidal agents
cause cell death; the terms fungistatic/fungicidal are
equivalent for antifungal agents, and virustatic/
virucidal for antiviral agents. The lowest concentration
of antimicrobial agent at which growth is inhibited is
the minimum inhibitory concentration (MIC), and
the lowest concentration that causes cell death is the
minimum bactericidal concentration (MBC). If the MIC
is less than or equal to a predetermined breakpoint
threshold, the organism is considered susceptible, and if
the MIC is greater than the breakpoint, it is resistant.
Breakpoints are determined for each antimicrobial
agent from a combination of pharmacokinetic and clinical
data. The relationship between in vitro antimicrobial
susceptibility and clinical response is complex, as
response also depends on immune status, pharmacokinetic variability , comorbidities that may influence pharmacokinetics or pharmacodynamics, and
antibiotic dosing, as well as MIC/MBC. Thus, susceptibility
testing does not guarantee therapeutic success.
Susceptibility testing is most often carried out by disc
diffusion . Antibiotic-impregnated filter paper
discs are placed on an agar plate containing bacteria.
The antibiotic diffuses through the agar, resulting in a
concentration gradient centred on the disc. Bacteria areunable to grow where the antibiotic concentration
exceeds the MIC, which may therefore be inferred from
the size of the zone of inhibition. Susceptibility testing
methods using antimicrobials diluted in liquid media
are generally more accurate and reproducible, and are
used for generating epidemiological data.
Fig. Antimicrobial susceptibility testing by disc diffusion.
The test organism is grown as a ‘lawn’ on an agar plate in the presence of antimicrobial-impregnated discs. The organism is considered susceptible if the diameter of the zone of inhibition exceeds a predetermined threshold.EPIDEMIOLOGY OF INFECTION
The communicability of infectious disease means that,once a clinician has diagnosed an infectious disease,
potential exposure of other patients must be considered. The patient may require treatment in isolation, or an
outbreak of disease may need to be investigated in the
community .
The approach will be specific to the microorganism involved but the principles are outlined below.
Geographic and temporal patterns of infection
Endemic diseaseEndemic disease has a constant presence within a given
geographic area or population. The infectious agent may
have a reservoir, vector or intermediate host that is
geographically restricted, or may itself have restrictive
environmental requirements (e.g. temperature range,
humidity).
The population affected may be geographically isolated, or the disease may be limited to unvaccinated populations.
Factors that alter geographical restriction include:
• expansion of an animal reservoir (e.g. Lyme disease
from reforestation)
• vector escape (e.g. airport malaria)
• extension of host range (e.g. schistosomiasis from
dam construction)
• human migration (e.g. severe acute respiratory
syndrome (SARS) coronavirus)
• public health service breakdown (e.g. diphtheria in
unvaccinated areas)
• climate change.
Emerging and re-emerging disease
An emerging infectious disease is one that has newlyappeared in a population, or has been known for some
time but is increasing in incidence or geographic range.
If the disease was previously known and thought to
have been controlled or eradicated, it is considered to be
re-emerging. Many emerging diseases are caused by
organisms which infect animals and have undergone
adaptations that enable them to infect humans. This is
exemplified by HIV, which is believed to have originated
in higher primates in Africa.
Reservoirs of infection
The US Centers for Disease Control (CDC) define a reservoir of infection as ‘one or more epidemiologically
connected populations or environments in which a
pathogen can be permanently maintained, and from
which infection is transmitted to a defined target population’.
Reservoirs of infection may be human, animal or
environmental.
Human reservoirs
Colonised individuals or those with clinical infectiousdisease may act as reservoirs, e.g. for Staph. aureus
(including MRSA), which is carried in the nares of
30–40% of humans, and C. difficile. For infected humans
to act as reservoirs, the infections caused must be long-lasting and/or non-fatal, at least in a proportion of those affected, to enable onward transmission (e.g. tuberculosis, sexually transmitted infections).
Humans are the only reservoir for some organisms (e.g. smallpox and measles).
Animal reservoirs
The World Health Organization (WHO) defines a zoonosisas ‘a disease or infection that is naturally transmissible
from vertebrate animals to humans’. The infected
animal may be asymptomatic. Zoonotic agents may be
transmitted via any of the routes described below.
Primary infection with zoonoses may be transmitted
onward between humans, causing secondary disease
(e.g. Q fever, brucellosis, Ebola).
Environmental reservoirs
Many infective pathogens are acquired from an environmental source. However, some of these are maintained in human or animal reservoirs, with the environment acting only as a conduit for infection.
Transmission of infection
Infectious agents may be transmitted by one or more of
the following routes:
• Respiratory route: inhalation.
• Faecal–oral route: ingestion of infectious material
originating from faecal matter.
• Sexually transmitted infections: direct contact between
mucous membranes.
• Blood-borne infections: direct inoculation of infected
blood or body fluids.
• Direct contact: very few organisms are capable of
causing infection by direct contact with intact skin.
Most infection by this route requires inoculation or
contact with damaged skin.
• Via a vector or fomite: the vector/fomite bridges
the gap between the infected host or reservoirand the uninfected host. Vectors are animate, and
include mosquitoes in malaria and dengue, fleas in
plague and humans in MRSA.
Fomites are inanimate, and include items such as door handles, water taps, ultrasound probes and so on, which are particularly associated with health care-associated
infection.
The likelihood of infection following transmission of
an infectious agent depends on organism factors and
host susceptibility. The number of organisms required
to cause infection or death in 50% of the exposed population is referred to as the ID50 (infectious dose) and
LD50 (lethal dose), respectively. The incubation period
is the time between exposure and development of
disease, and the period of infectivity is the period after
exposure during which the patient is infectious to others.
Knowledge of incubation periods and periods of infectivity
is important in controlling the spread of disease,
although for many diseases these estimates are imprecise.
Periods of infectivity in childhood
infectious diseases1Incubation periods of important infections1
Incubation periods of important infections1 – cont’d
Deliberate releaseThe deliberate release of infectious agents with the
intention of causing disease is known as biological
warfare or bioterrorism, depending on the scale and
context. Deliberate release incidents have included a
750-person outbreak of Salmonella typhimurium by contamination of salads in 1984 (Oregon, USA) and 22 cases of anthrax (five fatal) from the mailing of finely
powdered (weaponised) anthrax spores in 2001 (New
Jersey, USA). Diseases with high potential for deliberate
release include anthrax, plague, tularaemia, smallpox
and botulism (through toxin release).
INFECTION PREVENTION AND CONTROL (IPC)
Describes the measures applied to populations with the aim of breaking the chain of infection.Health care-acquired infection
Admission to a health-care facility in the developed world carries a considerable risk of acquiring infection, estimated by the UK Department of Health as 6–10%. Factors that contribute to health care-acquired infection (HCAI, or nosocomial infection) are shown in Figure. Many nosocomial bacterial infections are caused by organisms that are resistant to numerous antibiotics (multi-resistant bacteria), including MRSA , extended-spectrum β-lactamase (ESBL)-producing Enterobacteriaceae, glycopeptide-resistant enterococci (GRE) and carbapenemase-producing Enterobacteriaceae (CPE).
Other infections of particular concern in hospitals
include C. difficile and norovirus .
IPC measures are described in Box. The most
important infection prevention practice is maintenance
of good hand hygiene (Fig.). Hand decontamination
or washing is mandatory before and after every patient
contact. In most cases, decontamination with alcohol gel is adequate. However, hand-washing (with hot water,
liquid soap and complete drying) is required after any
procedure that involves more than casual physical
contact, or if hands are visibly soiled.
In situations where the prevalence of C. difficile is high (e.g. a local outbreak), alcohol gel decontamination between patient contacts is inadequate, as it does not kill C. difficile spores, and hands must be washed with soap and water.
Some infections necessitate additional measures to
prevent cross-infection .
To avoid infection, all invasive procedures must be performed with strict aseptic technique .
Fig.Commonly encountered health care-associated infections (HCAI) and the factors that predispose to them. (ESBL = extended spectrum β-lactamases; GRE = glycopeptide-resistant enterococci; MRSA = multidrug-resistant Staph. aureus; RSV = respiratory syncytial virus)
Hand-washing. Good hand hygiene, whether with soap/water or alcohol handrub, includes areas that are often missed, such as fingertips, web spaces, palmar creases and the backs of hands.
Institutional
• Handling, storage and disposal of clinical waste• Containment and safe removal of spilled blood and body fluids
• Cleanliness of environment and medical equipment
• Specialised ventilation (e.g. laminar flow, air filtration, controlled pressure gradients) • Sterilisation and disinfection of instruments and equipment • Food hygiene • Laundry management
Health-care staff
• Education
• Hand hygiene, including hand-washing
• Sharps management and disposal
• Use of personal protective equipment (masks, sterile and non-sterile gloves, gowns and aprons)
• Screening health workers for disease (e.g. tuberculosis,
hepatitis B virus, MRSA)
• Immunisation and post-exposure prophylaxis
Measures used in infection prevention and control (IPC)
Clinical practice
• Antibiotic stewardship (use only when necessary; avoid drugs known to select multi-resistant organisms or predispose to other infections)• Aseptic technique • Perioperative antimicrobial prophylaxis • Screening patients for colonisation or infection (e.g. MRSA, GRE, CPE)
Response to infections
• Surveillance to detect alert organism (see text) outbreaks and antimicrobial resistance
• Antibiotic chemoprophylaxis to infectious disease contacts, if • Isolation • Reservoir control • Vector control
Measures used in infection prevention and control (IPC) – cont’d
Types of isolation precaution1
Skin antisepsis prior to insertion of central venous catheters
Outbreaks of infectionDescriptive terms are defined in Box. Confirmation
of an infectious disease outbreak usually requires evidence
from typing that the causal organisms have identical genotypic characteristics. If this is found not to be the case, the term pseudo-outbreak is used.
When an outbreak of infection is suspected, a case
definition is agreed. The number of cases that meet the
case definition is then assessed by case-finding, using
methods ranging from administration of questionnaires
to national reporting systems. Case-finding usually
includes microbiological testing, at least in the early
stages of an outbreak.
Temporal changes in cases are noted in order to plot an outbreak curve, and demographic details are collected to identify possible sources of infection.
A case control study, in which recent activities (potential exposures) of affected ‘cases’ are compared to those of unaffected ‘controls’, may be undertaken to establish the outbreak source, and measures are taken to manage the outbreak and control its spread.
Good communication between relevant personnel during and after the outbreak is important to inform practice in future outbreaks.
Surveillance ensures that disease outbreaks are
either pre-empted or identified early. In hospitals, staffare made aware of the isolation of alert organisms,
which have the propensity to cause outbreaks, and alert
conditions, which are likely to be caused by such organisms.
Analogous systems are used nationally; many
countries publish lists of organisms and diseases, which,
if detected (or suspected), must be reported to public
health authorities (reportable or notifiable diseases).
Reasons for a disease to be classified as reportable are
shown in Box .
Terminology in outbreaks of infection
Terminology in outbreaks of infection – cont’d
Reasons for including an infectious disease
on a regional/national list of reportable diseasesPrinciples of food hygiene
‘Food poisoning’ is largely preventable by foodhygiene measures.
The main principles are:
• segregation of uncooked food (which may be
contaminated with pathogenic microorganisms) from cooked food
• avoidance of conditions which allow growth
of pathogenic bacteria before or after cooking
• adequate bacterial killing during cooking.
Safe storage depends on the temperatures at
which food bacteria are inhibited and destroyed
Important temperatures (°C) in food hygiene.
ImmunisationImmunisation may be passive or active.
Passive immunization is achieved by administering antibodies targeted against a specific pathogen. Antibodies are obtained from blood, so confer some of the risks associated with blood products .
The protection afforded by passive immunisation is immediate but of short duration (a few weeks or months); it is used to
prevent or attenuate infection before or after exposure.
Indications for post-exposure prophylaxis
with immunoglobulinsVaccination
Active immunisation is achieved by vaccination withwhole organisms or organism components (Box).
Types of vaccine
Whole cell vaccines consist of live or inactivated (killed)
microorganisms; component vaccines contain only
extracted or synthesised components of microorganisms
(e.g. polysaccharides or proteins).
Live vaccines contain organisms with attenuated (reduced) virulence, which induce T-lymphocyte and humoral responses and are therefore more immunogenic than inactivated whole cell vaccines.
The use of live vaccines in immunocompromised individuals requires careful consideration.
Component vaccines consisting only of polysaccharides,
such as the pneumococcal polysaccharide
vaccine (PPV), are poor activators of T-lymphocytes,
and produce a short-lived antibody response without
long-lasting memory.
Conjugation of polysaccharide to a protein, as in the Haemophilus influenzae type B (Hib)
vaccine, activates T lymphocytes, which results in a sustained response and immunological memory.
Toxoids are bacterial toxins that have been modified to reduce toxicity but maintain antigenicity. Vaccine response can be improved by co-administration with mildly proinflammatory adjuvants, such as aluminium hydroxide.
Use of vaccines
Vaccination may be applied to entire populations orto subpopulations at specific risk through travel, occupation
or other activities. In ring vaccination, the population
immediately surrounding a case or outbreak of infectious disease is vaccinated to curtail further spread.
Vaccination is aimed mainly at preventing infectious
disease.
However, vaccination against human papillomavirus (HPV) was introduced to prevent cervical and other cancers which complicate HPV infection. Vaccination guidelines for individuals are shown in Box.
Vaccination becomes successful once the number of
susceptible hosts in a population falls below the levelrequired to sustain continued transmission of the target
organism (herd immunity). Naturally acquired smallpox
was declared to have been eradicated worldwide
in 1980 through mass vaccination. In 1988, the WHO
resolved to eradicate poliomyelitis by vaccination; the
number of cases worldwide has since fallen from
approximately 350 000 per annum to 223 in 2012. Recommended vaccination schedules vary between countries.
In addition to standard vaccination schedules, catch-up
schedules are specified for individuals who join vaccination
programmes later than the recommended age.
Vaccines in current clinical use
Vaccines in current clinical use – cont’d
Guidelines for vaccination against
infectious diseaseTREATMENT OF INFECTIOUS DISEASES
The key components of treating infectious disease are:• addressing predisposing factors, e.g. diabetes
mellitus or known immune deficit (HIV, neutropenia)
• antimicrobial therapy
• adjuvant therapy, e.g. removal of an indwelling
catheter (urinary or vascular), abscess drainage or
débridement of an area of necrotising fasciitis
• treatment of the consequences of infection, e.g. the
systemic inflammatory response syndrome (SIRS;
inflammation and pain. For communicable disease, treatment must also take into account contacts of the infected patient, and may include infection prevention and control activities such as isolation, antimicrobial prophylaxis, vaccination and contact tracing.
Principles of antimicrobial therapy
When infection is diagnosed, it is important to start
appropriate antimicrobial therapy promptly. The principles
underlying the choice of antimicrobial agent(s) are discussed below. The process of selecting appropriate
antimicrobial therapy has been summarised in UK guidance
as ‘Start Smart – Then Focus. Fig.
Stages in the selection and refinement of antimicrobial therapy: ‘Start Smart – Then Focus’.
Antimicrobial action and spectrum
Antimicrobial agents kill microorganisms by inhibiting,damaging or destroying a target that is a required component of the organism. The range, or spectrum, of
microorganisms that is killed by a particular antimicrobial
agent must be considered in selecting therapy. The
mechanisms of action of the major classes of antibacterial
agent are listed in Box and appropriate antibiotic
choices for a range of common infecting organisms
are shown in Box. In severe infections and/or
immunocompromised patients, it is customary to use
bactericidal agents in preference to bacteriostatic agents.
Empiric versus targeted therapy
Empiric antimicrobial therapy is selected to treat a
clinical syndrome (e.g. meningitis) before a microbiological
diagnosis has been made. Targeted therapy is
aimed at the causal pathogen(s) of known antimicrobial
sensitivity. ‘Start Smart – Then Focus’ describes the principle of using appropriate broad-spectrum agents in
empiric therapy, followed by narrow-spectrum agents
in targeted therapy. Optimum empiric therapy depends
on the site of infection, patient characteristics and local
antimicrobial resistance patterns. Hospital antibiotic
policies are used to guide rational antimicrobial prescribing, maximising efficacy while minimising antimicrobial resistance and cost.
Combination therapy
It is sometimes appropriate to use antimicrobial agentsin combination:
• to increase efficacy (e.g. enterococcal endocarditis,
where a β-lactam/aminoglycoside combination results in better outcomes than a β-lactam alone)
• when no single agent’s spectrum covers all potential
pathogens (e.g. in polymicrobial infection or empiric
treatment of sepsis)
• to reduce antimicrobial resistance, as the organism
would need to develop resistance to multiple agents
simultaneously (e.g. antituberculous chemotherapy,
antiretroviral therapy.
Target and mechanism of action of common antibacterial agents
Target and mechanism of action of
common antibacterial agents – cont’dAntimicrobial options for common infecting bacteria
Antimicrobial options for common infecting bacteria– cont’d
Antimicrobial resistance
Microorganisms have evolved in the presence of naturallyoccurring antibiotics, and have therefore developed
resistance mechanisms (categorised in Fig.) to
all classes of antimicrobial agent (antibiotics and their
derivatives). Intrinsic resistance is an innate property of
a microorganism, whereas acquired resistance arises by
spontaneous mutation or horizontal transfer of genetic
material from another organism in a phage or plasmid. Plasmids often encode resistance to multiple antibiotics.
For some agents, e.g. penicillins, a degree of resistance
occurs in vivo when the bacterial load is high and the
molecular target for the antimicrobial is down-regulated
(an ‘inoculum effect’).
The mecA gene encodes a low-affinity penicillinbinding
protein, which confers resistance to β-lactamantibiotics in staphylococci. Extended spectrum β-
lactamases (ESBL) are encoded on plasmids which are
transferred relatively easily between bacteria, including
Enterobacteriaceae. Plasmid-encoded carbapenemases
have been detected in strains of Klebsiella pneumoniae
(e.g. New Delhi metallo-β-lactamase 1, NDM-1). Strains
of MRSA have been described that exhibit intermediate
resistance to glycopeptides (GISA) through the development of a relatively impermeable cell wall.
Factors promoting antimicrobial resistance include
the inappropriate use of antibiotics (e.g. in viral infections),
inadequate dosage or treatment duration, and use
of antimicrobials as growth-promoters in agriculture.
However, any antimicrobial use exerts a selection pressure
that favours the development of resistance.
Combination antimicrobial therapy may reduce the emergence of resistance. This is recommended in treatment of patients infected with HIV, which is highly prone to
spontaneous mutation .
Despite use of combination therapy for M. tuberculosis, multidrug-resistant tuberculosis (MDR-TB, resistant to isoniazid and rifampicin) and extremely drug-resistant tuberculosis (XDR-TB, resistant to isoniazid and rifampicin, any fluoroquinolone and at least one injectable antimicrobial antituberculous agent) have been reported worldwide and are increasing in incidence.
The term post-antibiotic era has been coined to
describe a future in which the acquisition of resistance
by bacteria will have been so extensive that antibiotic
therapy is rendered useless. A more realistic scenario,
which is currently being experienced, is a gradual but
inexorable progression of resistance, necessitating the
use of ever more toxic and expensive antimicrobials.
Fig-Examples of mechanisms of antimicrobial resistance.
(CAT = chloramphenicol acetyltransferase; ESBL = extended spectrum β-lactamases; GISA = glycopeptide-intermediate Staph. aureus;MRSA = meticillin-resistant Staph. aureus; NDM-1 = New Delhi metallo-β-lactamase 1).
Duration of therapy
Treatment duration reflects the severity of infection andaccessibility of the infected site to antimicrobial agents.
For most infections, there is limited evidence available to
support a specific duration of treatment (Box).
Depending on the indication, initial intravenous therapy
may be switched to oral after fever has settled for approximately 48 hours.
In the absence of specific guidance antimicrobial therapy should be stopped when there is no longer any clinical evidence of infection.
Duration of antimicrobial therapy for some
common infections*Duration of antimicrobial therapy for some
common infections*– cont’d
Antimicrobial prophylaxis
Primary prophylaxis is used when there is a risk of infectionfrom a procedure or exposure (Box). It should
be of short duration with minimal adverse effects, and
may be combined with passive immunisation (see Box ).
Secondary prophylaxis is used in patients who
have been treated successfully for an infection but
remain predisposed to it. It is used in haemato-oncology
patients in the context of fungal infection and in HIVpositive
individuals with an opportunistic infection who
do not respond to antiretroviral therapy.
Recommendations for antimicrobial
prophylaxis in adults*Recommendations for antimicrobial
prophylaxis in adults *– cont’d*These are based on current UK practice. Recommendations may vary
locally or nationally. Antimicrobial prophylaxis for infective endocarditisduring dental procedures is not currently recommended in the UK.
Pharmacokinetics and pharmacodynamics
Pharmacokinetics of antimicrobial agents determinewhether adequate concentrations are obtained at the
sites of infection. Septic patients often have poor gastrointestinal absorption, so the preferred initial route of
therapy is intravenous. Knowledge of anticipated antimicrobial drug concentrations at sites of infection is critical.
For example, achieving a ‘therapeutic’ blood level of
gentamicin is of little practical use in treating meningitis,
as CSF penetration of the drug is poor. Knowledge of
routes of antimicrobial elimination is also critical; for
instance, urinary tract infection is ideally treated with a
drug that is excreted unchanged in the urine.
Pharmacodynamics describes the relationship
between antimicrobial concentration and microbial killing. For many agents, antimicrobial effect can be categorised
as concentration-dependent or time-dependent.
The concentration of antimicrobial achieved after a
single dose is illustrated in Figure. The maximum
concentration achieved is Cmax and the measure of overall exposure is the area under the curve (AUC). The efficacy of antimicrobial agents whose killing is concentration-dependent (e.g.aminoglycosides) increases with the amount by which Cmax exceeds the minimum inhibitory concentration (Cmax : MIC ratio).
For this reason, it has become customary to administer aminoglycosides (e.g. gentamicin) infrequently at high doses (e.g. 7 mg/kg) rather than frequently at low doses.
This has the added advantage of minimising toxicity by reducing the likelihood of drug accumulation.
Conversely, the β-lactam antibiotics, macrolides and clindamycin exhibit time-dependent killing, and their efficacy depends on Cmax exceeding the MIC for a certain time (which is different for each class of agent). This is reflected in the dosing interval of benzylpenicillin, which is usually given every 4 hours in severe infection (e.g. meningococcal meningitis), and may be administered by continuous infusion.
For other antimicrobial agents, the pharmacodynamic
relationships are more complex and often less well
understood. With some agents, bacterial inhibition persists
after antimicrobial exposure (post-antibiotic and
post-antibiotic sub-MIC effects).
Fig. Antimicrobial pharmacodynamics. The curve represents drug concentrations after a single dose of an antimicrobial agent. Factors that determine microbial killing are Cmax : MIC ratio (concentrationdependent killing), time above MIC (time-dependent killing) and AUC : MIC ratio.
Therapeutic drug monitoring
Therapeutic drug monitoring is used to confirm that
levels of antimicrobial agents with a low therapeutic index (e.g. aminoglycosides) are not excessive, and that
levels of agents with marked pharmacokinetic variability
(e.g. vancomycin) are adequate. Specific recommendations
for monitoring depend on individual clinical
circumstances; for instance, different pre- and post-dose
levels of gentamicin are recommended, depending on
whether it is being used in traditional divided doses,
once daily or for synergy in endocarditis.
Beta-lactam antibiotics
These antibiotics have a β-lactam ring structure and exert a bactericidal action by inhibiting enzymes involved in cell wall synthesis (penicillin-binding proteins, PBP). Pharmacokinetics• Good drug levels achieved in lung, kidney, bone, muscle , liver, pleural, synovial, pericardial and peritoneal fluids.
• CSF level low, except in the presence of inflammation.
• Activity is not inhibited in abscess (e.g. by low pH
and PO2, high protein or neutrophils).
• Beta-lactams are subject to an ‘inoculum effect’– activity is reduced in the presence of a high organism burden (PBP expression is downregulated by high organism density).
• Generally safe in pregnancy (except imipenem/cilastatin).
Beta-lactam antibiotics
Adverse effectsGeneralised allergy to penicillin occurs in 0.7–10% of
cases and anaphylaxis in 0.004–0.015%. A large proportion of patients with infectious mononucleosis develop a rash if given aminopenicillins; this does not imply
lasting allergy. The relationship between allergy to penicillin and allergy to cephalosporins depends on the specific cephalosporin used. Although there is significant
cross-reactivity with first-generation cephalosporins,
cross-reactivity to second- and third-generation cephalosporins is less common.
However, avoidance of cephalosporins is recommended in patients who have a type 1 penicillin allergy .
Cross-reactivity between penicillin and carbapenems is rare (approximately 1% by skin-prick testing). Although avoidance of carbapenems is recommended in penicillin-allergic patients, these drugs may be administered if there are no suitable alternatives and appropriate resuscitation facilities are available. Gastrointestinal upset and diarrhoea are common, and a mild reversible hepatitis is recognised with many β-lactams. Thrombocytopenia , leucopenia, and coagulation deficiencies, and interstitial nephritis and potentiation of aminoglycoside-mediated renal damage are also recognised . encephalopathy and Seizures have been reported, particularly with high doses in the presence of renal insufficiency. Thrombophlebitis occurs in up to 5% receiving parenteral β-lactams.
Drug interactions
Synergism occurs in combination with aminoglycosides.Ampicillin decreases the biological effect of oral contraceptives and the whole class is significantly affected by concurrent administration of probenecid, producing a
2–4-fold increase in the peak serum concentration.
Antimicrobial agents in pregnancy
• Clostridium difficile infection: all antibiotics predispose to
some extent, but second- and third-generation cephalosporins and co-amoxiclav especially so.• Hypersensitivity reactions: rise in incidence due to
increased previous exposure.
• Renal impairment: may be significant in old age, despite
‘normal’ creatinine levels .
• Nephrotoxicity: more likely, e.g. first-generation
cephalosporins, aminoglycosides.
• Accumulation of β-lactam antibiotics: may result in
myoclonus, seizures or coma.
• Reduced gastric acid production: gastric pH is higher,
which causes increased penicillin absorption.
• Reduced hepatic metabolism: results in a higher risk of
isoniazid-related hepatotoxicity.
• Quinolones: confusion and may increase the risk of seizures.
Problems with antimicrobial therapy in old age
Penicillins
Natural penicillins are primarily effective against Gram-positive organisms (except staphylococci, most of which produce a penicillinase) and anaerobic organisms. Strep. pyogenes has remained sensitive to natural penicillins
worldwide. According to the European Antimicrobial Resistance Surveillance Network (EARS-Net), the prevalence of high-level penicillin resistance in Strep. Pneumoniae in Europe in 2010 was 2.7%. However, the prevalence in individual countries was as high as 33% (Cyprus). Penicillinase-resistant penicillins are the mainstay of treatment for infections with Staph. aureus, other than
meticillin-resistant strains (MRSA). However, EARS-Net
data from 2010 indicate that almost 1 : 5 (18.5%) Staph.
aureus isolates in Europe were MRSA.
Aminopenicillins have the same spectrum of activity
as the natural penicillins, with additional Gram-negativecover against Enterobacteriaceae. Amoxicillin has better
oral absorption than ampicillin. Unfortunately, resistance
to these agents is widespread, so they are no longer
appropriate for first-line use in Gram-negative infections.
In many organisms, resistance is due to β-lactamase
production, which can be overcome by the addition of
β-lactamase inhibitors (clavulanic acid or sulbactam).
Carboxypenicillins (e.g. ticarcillin) and ureidopenicillins
(e.g. piperacillin) are particularly active against
Gram-negative organisms, especially Pseudomonas spp.
which are resistant to the aminopenicillins. Betalactamase
inhibitors may be added to extend their spectrum
of activity (e.g. piperacillin–tazobactam).
Cephalosporins and cephamycins Cephalosporins are reliable broad-spectrum agents. Unfortunately, their use is associated with C. difficile infection .With the exception of ceftobiprole, the group has no activity against Enterococcus spp. Only the cephamycins have significant anti-anaerobic activity. All cephalosporins are inactivated by ESBL.
Cephalosporins are arranged in ‘generations’ (Box).
• First-generation compounds have excellent activity
against Gram-positive organisms and some activity
against Gram-negatives.
• Second-generation drugs retain Gram-positive activity
but have extended Gram-negative activity. Cephamycins (e.g. cefoxitin), included in this group, are active against anaerobic Gram-negative bacilli.
• Third-generation agents further improve anti-Gram-negative cover. For some (e.g. ceftazidime), this is extended to include Pseudomonas spp. Cefotaxime and ceftriaxone have excellent Gram-negative activity and retain good activity against Strep. pneumoniae and β-haemolytic streptococci.
Ceftriaxone is administered once daily, and is therefore a suitable agent for outpatient antimicrobial therapy.
• Fourth-generation agents have an extremely broad
spectrum of activity, including Pseudomonas spp.,
Staph. aureus and streptococci.
• ‘Next generation’ agents have a third- or fourth-generation spectrum enhanced to include MRSA.
Cephalosporins
MonobactamsAztreonam is the only available monobactam. It is excellent
against Gram-negative, except ESBL-producing,
organisms, but no useful activity against Gram-positive
organisms or anaerobes. It is a parenteral-only agent and
may be used safely in penicillin-allergic patients.
Carbapenems
These intravenous agents have the broadest antibiotic
activity of the β-lactam antibiotics, covering most clinically
significant bacteria, including anaerobes.
Macrolide and lincosamide antibiotics
Macrolides (erythromycin, clarithromycin and azithromycin)
and lincosamides (lincomycin and clindamycin) are bacteriostatic agents which have related properties. Both classes bind to the same component of the ribosome,
so they are potentially competitive and should not be administered together. Macrolides are used for Gram-positive infections in penicillin-allergic patients and in Mycoplasma and Chlamydia infections. Erythromycin
is administered 4 times daily and clarithromycin twice daily. The long intracellular half-life of Azithromycin allows single-dose/short-course therapy for genitourinary Chlamydia/Mycoplasma spp. infections. Clarithromycin and azithromycin are also used to treat legionellosis.
Pharmacokinetics
Macrolides• Variable bioavailability.
• Short half-life (except azithromycin).
• High protein binding.
• Excellent intracellular accumulation.
Lincosamides (e.g. clindamycin)
• Good bioavailability.
• Food has no effect on absorption.
• Limited CSF penetration.
Adverse effects
• Gastrointestinal upset, especially in young adults(erythromycin 30%).
• Cholestatic jaundice with erythromycin estolate.
• Prolongation of QT interval on ECG, potential for
torsades de pointes.
• Clindamycin predisposes to C. difficile infection.
Ketolides
The ketolides were developed in response to the
emergence of penicillin and macrolide resistance in
respiratory pathogens. Cross-resistance with macrolides
is uncommon.
Telithromycin is administered orally and has useful activity against common bacterial causes of respiratory infection, as well as Mycoplasma, Chlamydia and Legionella spp.
Aminoglycosides
Aminoglycosides are effective mainly in Gram-negativeinfections. They act synergistically with β-lactam antibiotics and are particularly useful where β-lactam or
quinolone resistance occurs in health care-acquired
infections. They cause very little local irritation at injection
sites and negligible allergic responses. Oto- and
nephrotoxicity must be avoided by monitoring of renal
function and drug levels and by use of short treatment
regimens. Aminoglycosides are not subject to an inoculum
effect and they all exhibit a post-antibiotic effect.
Pharmacokinetics
• Negligible oral absorption.• Hydrophilic, so excellent penetration to extracellular
fluid in body cavities and serosal fluids.
• Very poor intracellular penetration (except hair cells
in cochlea and renal cortical cells).
• Negligible CSF and corneal penetration.
• Peak plasma levels 30 minutes after infusion.
• Monitoring of therapeutic levels required.
Gentamicin dosing
• Except in certain forms of endocarditis, pregnancy,
severe burns, end-stage renal disease and paediatric
patients, gentamicin is administered at 7 mg/kg
body weight. The appropriate dose interval depends on drug clearance, and is determined by reference to the Hartford nomogram (Fig.).
• In streptococcal and enterococcal endocarditis,
gentamicin is used with a cell wall active agent (usually a β-lactam), to provide synergy. The usual dose is 1 mg/kg/day 3 times daily for enterococcal endocarditis and 3 mg/kg once a day for most strains of viridans streptococci. Target pre- and post-dose levels are < 1 mg/L and 3–5 mg/L respectively when gentamicin is dosed 3 times daily.
• When not used once daily or for endocarditis,
gentamicin is administered twice or 3 times daily at3–5 mg/kg/day. Target pre- and post-dose levels
are < 1 mg/L and 5–10 mg/L (7–10 mg/L with less
sensitive organisms, e.g. Pseudomonas spp.)
respectively.
• For other aminoglycosides, consult local guidance.
Dosing of aminoglycosides using the Hartford nomogram. The nomogram is used to determine the dose interval for 7 mg doses of gentamicin or tobramycin, using measurements of drug levels in plasma 6–14 hours after a single dose.
Adverse effects
• Renal toxicity (usually reversible) accentuated by
other nephrotoxic agents.
• Cochlear toxicity (permanent) more likely in older
people and those with a predisposing mitochondrial
gene mutation.
• Neuromuscular blockade after rapid intravenous
infusion (potentiated by calcium channel blockers,
myasthenia gravis and hypomagnesaemia).
Quinolones and fluoroquinolones
These are effective and generally well-tolerated bactericidal agents. The quinolones have purely anti-Gram-negative activity, whereas the fluoroquinolones arebroad-spectrum agents (Box). Ciprofloxacin has
anti-pseudomonal activity but resistance emerges
rapidly. In 2010, 21% of E. coli isolates were resistant to
fluoroquinolones in Europe.
Quinolones and fluoroquinolones
Pharmacokinetics
• Well absorbed after oral administration butdelayed by food, antacids, ferrous sulphate and
multivitamins.
• Wide volume of distribution; tissue concentrations
twice those in serum.
• Good intracellular penetration, concentrating in
phagocytes.
Adverse effects
• Gastrointestinal side-effects in 1–5%.• Rare skin reactions (phototoxicity).
• Achilles tendon rupture is reported, especially in
older people.
• CNS effects (confusion, tremor, dizziness and
occasional seizures in 5–12%), especially in older
people.
• Reduces clearance of xanthines and theophyllines,
potentially inducing insomnia and increased seizure
potential.
• Reports of prolongation of QT interval on ECG with
newer fluoroquinolones.
• Cases of hypo- or hyperglycaemia in association
with gatifloxacin, so glucose monitoring is needed
in patients with diabetes or those with severe
hepatic dysfunction.
• Ciprofloxacin use is associated with the acquisition
of MRSA and emergence of C. difficile ribotype 027.
Glycopeptides
Glycopeptides (vancomycin and teicoplanin) are effectiveagainst Gram-positive organisms only, and are
used against MRSA and ampicillin-resistant enterococci.
Some staphylococci and enterococci demonstrate
intermediate sensitivity or resistance.
Vancomycin use should be restricted to limit emergence of resistant strains. Teicoplanin is not available in all countries.
Neither drug is absorbed after oral administration, but
vancomycin is used orally to treat C. difficile infection.
Pharmacokinetics
Vancomycin• Administered by slow intravenous infusion, good
tissue distribution and short half-life.
• Enters the CSF only in the presence of inflammation.
• Therapeutic monitoring of intravenous vancomycin
is recommended, to maintain pre-dose levels of
> 10 mg/L (15–20 mg/L in serious staphylococcal
infections).
Teicoplanin
• Long half-life allows once-daily dosing.
Adverse effects
• Histamine release due to rapid vancomycin infusion
produces a ‘red man’ reaction (rare with modern
preparations).
• Nephrotoxicity is rare, but may occur with
concomitant aminoglycoside use, as may
ototoxicity.
• Teicoplanin can cause rash, bronchospasm,
eosinophilia and anaphylaxis.
Folate antagonists
These bacteriostatic antibiotics interfere with the bacterialsynthesis of folic acid from para-aminobenzoic
acid. A combination of a sulphonamide and either
trimethoprim or pyrimethamine is most commonly
used, which interferes with two consecutive steps in
the metabolic pathway. Available combinations include
trimethoprim/sulfamethoxazole (co-trimoxazole) and
pyrimethamine with either sulfadoxine (used to treat
malaria) or sulfadiazine (used in toxoplasmosis). Co-trimoxazole in high dosage (120 mg/kg daily in 2–4
divided doses) is the first-line drug for Pneumocystis
jirovecii (carinii) infection.
The clinical use of these agents is limited by adverse effects. Folinic acid should be given if they are used long-term or unavoidably in early pregnancy.
Pharmacokinetics
• Well absorbed orally.
• Sulphonamides are hydrophilic, distributing well to
the extracellular fluid.
• Trimethoprim is lipophilic with high tissue
concentrations.
Adverse effects
• Trimethoprim is generally well tolerated, with fewadverse effects.
• Sulphonamides and dapsone may cause haemolysis
in glucose-6-phosphate dehydrogenase deficiency.
• Sulphonamides and dapsone cause skin and
mucocutaneous reactions, including Stevens– Johnson syndrome and ‘dapsone syndrome’ (rash, fever and lymphadenopathy).
• Dapsone causes methaemoglobinaemia and
peripheral neuropathy.
Tetracyclines and glycylcyclines
TetracyclinesOf this mainly bacteriostatic class, the newer drugs
doxycycline and minocycline show better absorption
and distribution than older ones. Most streptococci and
Gram-negative bacteria are now resistant, in part due to
use in animals (which is banned in Europe). Tetracyclines
are indicated for Mycoplasma spp., Chlamydia
spp., Rickettsia spp., Coxiella spp., Bartonella spp., Borrelia
spp., Helicobacter pylori, Treponema pallidum and atypical
mycobacterial infections. Minocycline is occasionally
used in chronic staphylococcal infections.
Pharmacokinetics
• Best oral absorption is in the fasting state (doxycycline is 100% absorbed unless gastric pH rises).
Adverse effects
• All tetracyclines except doxycycline are contraindicated in renal failure.
• Dizziness with minocycline.
• Binding to metallic ions in bones and teeth causes
discoloration (avoid in children and pregnancy) and
enamel hypoplasia.
• Phototoxic skin reactions.
Glycylcyclines (tigecycline)
Chemical modification of tetracycline has produced tigecycline, a broad-spectrum, parenteral-only antibioticwith activity against resistant Gram-positive and Gram-negative pathogens, such as MRSA and ESBL (but
excluding Pseudomonas spp.). Re-analysis of trial data
has shown that there was excess mortality following
tigecycline treatment compared with comparator antibiotics, so tigecycline should be used only when there
are no available alternative agents.
Nitroimidazoles
Nitroimidazoles are highly active against strictly anaerobicbacteria, especially Bacteroides fragilis, C. difficile and
other Clostridium spp. They also have significant antiprotozoal activity against amoebae and Giardia.
Pharmacokinetics
• Almost completely absorbed after oral administration (60% after rectal administration).
• Well distributed, especially to brain and CSF.
• Safe in pregnancy.
Adverse effects
• Metallic taste (dose-dependent).
• Severe vomiting if taken with alcohol – ‘Antabuse effect’.
• Peripheral neuropathy with prolonged use.
Other antibacterial agents
Anti-tuberculous agents are discussed.
Chloramphenicol
This is a potent and cheap antibiotic, still widely prescribed
throughout the world despite its potential toxicity.
Its use is increasingly reserved for severe and
life-threatening infections where other antibiotics are
either unavailable or impractical. It is bacteriostatic to
most organisms but apparently bactericidal to H. influenzae, Strep. pneumoniae and Neisseria meningitidis. It has a very broad spectrum of activity against aerobic and
anaerobic organisms, spirochaetes, Rickettsia, Chlamydia
and Mycoplasma spp. It also has quite useful activity
against anaerobes, such as B. fragilis.
It competes with macrolides and lincosamides for ribosomal binding sites, so should not be used in combination with these agents. Significant adverse effects are ‘grey baby’ syndrome in infants (cyanosis and circulatory collapse due
to inability to conjugate drug and excrete the active form
in urine); reversible dose-dependent bone marrow
depression in adults receiving high cumulative doses;
and severe aplastic anaemia in 1 in 25 000–40 000 exposures (unrelated to dose, duration of therapy or route of administration).
Daptomycin
Daptomycin is a cyclic lipopeptide with bactericidalactivity against Gram-positive organisms (including
MRSA and GRE) but not Gram-negatives. It is not
absorbed orally, and is used intravenously to treat resistant
Gram-positive infections, e.g. soft tissue infections
and infective endocarditis, if other options are not
available.
Treatment can be associated with increased levels of creatine kinase and patients receiving lipid-lowering statins should discontinue these to avoid myopathy.
Fusidic acid
This antibiotic, active against Gram-positive bacteria, is
available in intravenous, oral or topical formulations.
It is lipid-soluble and distributes well to tissues. However,
its antibacterial activity is unpredictable. Fusidic
acid is used in combination, typically with antistaphylococcal penicillins, or for MRSA with clindamycin or rifampicin. It interacts with coumarin derivatives and
oral contraceptives.
Nitrofurantoin
This drug has very rapid renal elimination and is activeagainst aerobic Gram-negative and Gram-positive bacteria, including enterococci. It is used only for treatment
of urinary tract infection, being generally safe in pregnancy and childhood.
However, with prolonged use, it can cause eosinophilic lung infiltrates, fever, pulmonary fibrosis, peripheral neuropathy, hepatitis and haemolytic anaemia.
Linezolid
Linezolid is the only currently licensed oxazolidinoneantibiotic. It shows excellent oral absorption with good
activity against Gram-positive organisms, including
MRSA and GRE. It is competitively inhibited by
co-administration of chloramphenicol, vancomycin or
clindamycin. Common adverse effects include mild
gastrointestinal upset and tongue discoloration. Myelodysplasia and peripheral neuropathy can occur with prolonged use. Linezolid has MAOI activity and co-administration with other MAOIs or serotonin re-uptake inhibitors should be avoided, as this may precipitate a serotonin syndrome (neuromuscular effects, autonomic hyperactivity and altered mental status).
Fidaxomicin
Fidaxomicin is an inhibitor of RNA synthesis, which was
introduced for the treatment of C. difficile infection (CDI)
in 2012. In non-severe CDI, it appears to be non-inferior
to oral vancomycin and is associated with a lower recurrence rate. Its effectiveness has not been assessed in
severe CDI.
Spectinomycin
Chemically similar to the aminoglycosides and given
intramuscularly, spectinomycin was developed to treat
strains of N. gonorrhoeae resistant to β-lactam antibiotics.
Unfortunately, resistance to spectinomycin is very
common. Its only indication is the treatment of gonococcal
urethritis in pregnancy or in patients allergic to
β-lactam antibiotics.
Streptogramins
Quinupristin/dalfopristin (supplied as a 30 : 70% combination) is active against MRSA and GRE (Enterococcusfaecium but not E. faecalis), and its use should be reserved
for these organisms. It is available in intravenous formulation only and shows good tissue penetration, but does not cross the blood–brain barrier or the placenta. Significant phlebitis occurs at injection sites and a raised serum creatinine and eosinophilia may occur.
Antifungal agents
See BoxAzole antifungals
The azoles (imidazoles and triazoles) inhibit synthesis of
ergosterol, a constituent of the fungal cell membrane.
Side-effects vary but include gastrointestinal upset, hepatitis and rash. Azoles are inhibitors of cytochrome p450 enzymes, so tend to increase exposure to cytochrome
p450-metabolised drugs .
Antifungal agents
ImidazolesMiconazole, econazole, clotrimazole and ketoconazole
are relatively toxic and therefore mainly administered
topically. Clotrimazole is used extensively to treat
superficial fungal infections. Ketoconazole may be given
orally, but causes severe hepatitis in 1 : 15 000 cases and
inhibits enzymes involved in steroid hormone biosynthesis.
Triazoles are preferred for systemic administration
because of their reduced toxicity.
Triazoles
Fluconazole is effective against yeasts (Candida andCryptococcus spp.). It is well absorbed after oral administration, and has a long half-life (approximately
30 hours) and an excellent safety profile. The drug is
highly water-soluble and distributes widely to all body
sites and tissues, including CSF. Itraconazole is lipophilic and distributes extensively, including to toenails and fingernails. CSF penetration is poor. Oral absorption is erratic and formulation- dependent, necessitating therapeutic drug monitoring. Voriconazole is well absorbed (96% oral bioavailability) and used mainly in aspergillosis .
Posaconazole is the broadest-spectrum antifungal
azole, and the only one with consistent activity against
mucoraceous moulds. It is available as an oral agent only.
Echinocandins
The echinocandins inhibit β-1,3-glucan synthesis in the
fungal cell wall. They have few significant adverse
effects. Caspofungin, anidulafungin and micafungin are
used to treat systemic candidosis, and caspofungin is
also used in aspergillosis.
Polyenes
Amphotericin B (AmB) deoxycholate causes cell death
by binding to ergosterol and damaging the fungal cytoplasmic membrane. Its use in resource-rich countries
has been largely supplanted by less toxic agents. It
is lipophilic, insoluble in water and not absorbed orally.
Its long half-life enables once-daily administration. CSF
penetration is poor.
Adverse effects include immediate anaphylaxis,
other infusion-related reactions and nephrotoxicity.Nephrotoxicity may be sufficient to require dialysis, and
occurs in most patients who are adequately dosed. It
may be ameliorated by concomitant infusion of normal
saline. Irreversible nephrotoxicity occurs with large
cumulative doses of AmB.
Nystatin has a similar spectrum of antifungal activity
to AmB. Its toxicity limits it to topical use, e.g. in oral
and vaginal candidiasis.
Lipid formulations of amphotericin B
Lipid formulations of AmB have been developed to
reduce AmB toxicity. They consist of AmB encapsulated
in liposomes (liposomal AmB, L-AmB) or complexed
with phospholipids (AmB lipid complex, ABLC). The
drug becomes active on dissociating from its lipid component.
Adverse effects are similar to, but considerably
less frequent than, those with AmB deoxycholate, and
efficacy is similar. Lipid formulations of AmB are used
in invasive fungal disease, as empirical therapy in
patients with neutropenic fever , and also in visceral leishmaniasis.
Other antifungal agents
FlucytosineThis drug has particular activity against yeasts. When
used as monotherapy, resistance develops rapidly, so it
should be administered in combination with another
antifungal agent.
Oral dosing is effective. Adverse effects include myelosuppression, gastrointestinal upset and hepatitis.
Griseofulvin
Griseofulvin has been largely superseded by terbinafineand itraconazole for treatment of dermatophyte infections,
except in children, for whom these agents remain
largely unlicensed. It demonstrates excellent oral bioavailability and is deposited in keratin precursor cells,
which become resistant to fungal invasion. The duration
of treatment is 2–4 weeks for tinea corporis/capitis,
4–8 weeks for tinea pedis, and 4–6 months for onychomycosis (fungal nail infections).
Terbinafine
Terbinafine is well absorbed orally, can be given
once daily and distributes with high concentration to
sebum and skin, with a half-life of more than 1 week.
It is used topically for dermatophyte skin infections
and orally for onychomycosis.
The major adverse reaction is hepatic toxicity (approximately 1 : 50 000 cases). Terbinafine is not recommended for breastfeeding mothers.
Antiviral agents
Most viral infections in immunocompetent individualsresolve without intervention. Antiviral therapy is available for a limited number of infections only.
Antiretroviral agents
These agents, used predominantly against HIV, are discussed.
Antiviral agents
Antiviral agents– cont’d
Anti-herpesvirus agentsAciclovir, valaciclovir, penciclovir and famciclovir
Aciclovir, valaciclovir, penciclovir and famciclovir are
acyclic analogues of guanosine, which inhibit viral
DNA polymerase after being phosphorylated by virus-derived thymidine kinase (TK). Aciclovir is poorly
absorbed after oral dosing; better levels are achieved
intravenously or by use of the prodrug valaciclovir.
Famciclovir is the prodrug of penciclovir. Resistance is
mediated by viral kinase or polymerase mutations.
Ganciclovir
Chemical modification of the aciclovir molecule allowspreferential phosphorylation by protein kinases of
CMV and other β-herpesviruses (e.g. human herpesvirus (HHV) 6/7) and hence greater inhibition of the DNA polymerase, but at the expense of increased toxicity. Ganciclovir is administered IV or as a prodrug (valganciclovir) orally.
Cidofovir
Cidofovir inhibits viral DNA polymerases with potent
activity against CMV. It also has activity against acyclovir -resistant herpes simplex virus (HSV) and varicella zoster virus (VZV), HHV6 and occasionally adenovirus, poxvirus, papillomavirus or polyoma virus, and may be used to treat these infections in immunocompromised hosts.
Foscarnet
This analogue of inorganic pyrophosphate acts as a noncompetitive inhibitor of HSV, VZV, HHV6/7 or CMV
DNA polymerase. It does not require significant intracellular phosphorylation and so may be effective when
HSV or CMV resistance is due to altered drug phosphorylation.
It has variable CSF penetration.
Anti-influenza agents
Zanamivir and oseltamivirInhibit influenza A and B neuraminidase,which is required for release of virus from infected cells .They are used in treatment and prophylaxis of influenza. Administration within 48 hours of onset reduces the duration of symptoms by 1–1½ days. In the UK, their use is limited mainly to adults with chronic respiratory or renal disease, significant CVD, immunosuppression or diabetes, during known outbreaks. Peramivir has a distinct structure, which means that it retains activity against some oseltamivir and zanamivir-resistant strains. It has poor oral bioavailability and is being developed as an IV or IM formulation. An
IV zanamivir is in development for critically ill patients.
Amantadine and rimantadine
These drugs reduce replication of influenza A by inhibitionof viral M2 protein ion channel function, which
is required for uncoating .
Resistance develops rapidly and is widespread, and amantadine and rimantadine should be used only if the
prevalence of resistance locally is known to be low.
They are no longer recommended for treatment or
prophylaxis in the UK or USA, having been superseded
by zanamivir and oseltamivir.
However, they may still be indicated to treat oseltamivir-resistant influenza A in patients unable to take zanamivir (e.g. ventilated patients).
Agents used against hepatitis viruses
Ribavirin
Ribavirin is a guanosine analogue that inhibits nucleic
acid synthesis in a variety of viruses and is used in particular in the treatment of hepatitis C virus.
Lamivudine, adefovir dipivoxil, tenofovir, entecavir and telbivudine
These agents have excellent activity against hepatitis
B virus DNA polymerase–reverse transcriptase. They
are well tolerated after oral administration but resistance
develops with monotherapy. Resistance seems to emerge most rapidly for lamivudine (via the tyrosine–methionine–aspartate–aspartate, or YMDD, mutation) and most slowly for entecavir (multiple mutations required).
Organisms resistant to lamivudine are usually also resistant to telbivudine, but not to adefovir/tenofovir.
The role of monotherapy for hepatitis B virus is currently a matter for debate, and combination therapy, as used in HIV treatment, is likely to be increasingly employed.
Lamivudine and tenofovir are also used against HIV.
Telaprevir and boceprevir
A number of antiviral inhibitors of the hepatitis C virusNS3 serine protease or NS5B polymerase are in development. Telaprevir and boceprevir have been licensed for use in chronic hepatitis C virus genotype 1 disease. Addition of these agents to standard interferon–ribavirin combination therapy improves sustained virological response rates. Resistance develops so they are administered as part of combination treatment.
Interferon-α
Naturally occurring cytokines that are produced as an early response to viral infection. The addition of a polyethylene glycol (PEG) moiety to the molecule significantly enhances pharmacokinetics and efficacy.
Antiparasitic agents
Drugs used against helminthsBenzimidazoles (albendazole, mebendazole)
These agents act by inhibiting both helminth glucose
uptake, causing depletion of glycogen stores, and fumarate
reductase. Albendazole is used for hookworm,
ascariasis, threadworm, Strongyloides infection, trichinellosis, Taenia solium (cysticercosis) and hydatid disease.
Mebendazole is used for hookworm, ascariasis, threadworm and whipworm. The drugs are administered
orally. Absorption is relatively poor, but increased by a
fatty meal. Significant adverse effects are uncommon.
Bithionol
Bithionol is used to treat fluke infections with Fasciola
hepatica. It is well absorbed orally. Adverse effects are
mild (e.g. nausea, vomiting, diarrhoea, rashes) but relatively common (approximately 30%).
Diethylcarbamazine
Diethylcarbamazine (DEC) is an oral agent used to treat
filariasis and loiasis. Treatment of filariasis is often followed by fever, headache, nausea, vomiting, arthralgia
and prostration. This is caused by the host response to
dying microfilariae, rather than the drug, and may be
reduced by pre-treatment with corticosteroids.
Ivermectin
Ivermectin binds to helminth nerve and muscle cellion channels, causing increased membrane permeability.
It is an oral agent, used in Strongyloides infection,
filariasis and onchocerciasis. Significant side-effects are
uncommon.
Niclosamide
Niclosamide inhibits oxidative phosphorylation, causing
paralysis of helminths. It is an oral agent, used in Taenia
saginata and intestinal T. solium infection. Systemic
absorption is minimal and it has few significant side-effects.
Piperazine
Piperazine inhibits neurotransmitter function, causing
helminth muscle paralysis. It is an oral agent, used in
ascariasis and threadworm (Enterobius vermicularis)
infection. Significant adverse effects are uncommon, but
include neuropsychological reactions such as vertigo,
confusion and convulsions.
Praziquantel
Praziquantel increases membrane permeability to Ca++,
causing violent contraction of worm muscle. It is the drug of choice for schistosomiasis, and is also used in T. saginata, T. solium (cysticercosis) and fluke infections (Clonorchis, Paragonimus) and in echinococcosis. It is administered orally and is well absorbed. Adverse effects are usually mild and transient, and include nausea and abdominal pain.
Pyrantel pamoate
This agent causes spastic paralysis of helminth musclethrough a suxamethonium-like action. It is used orally
in ascariasis and threadworm infection. Systemic absorption
is poor and adverse effects are uncommon.
Thiabendazole
Thiabendazole inhibits fumarate reductase, which is
required for energy production in helminths.
It is used orally in Strongyloides infection and topically to treat cutaneous larva migrans. Significant adverse effects are uncommon.
Antimalarial agents
Artemisinin (quinghaosu) derivatives
Artemisinin originates from a herb (sweet wormwood,
Artemisia annua), which was used in Chinese medicine
to treat fever. Its derivatives, artemether and artesunate,
were developed for use in malaria in the 1970s. Their
mechanism of action is unknown. They are used in the
treatment, but not prophylaxis, of malaria, usually in
combination with other antimalarials, and are effective
against strains of Plasmodium spp. that are resistant to
other antimalarials. Artemether is lipid-soluble and may be administered via intramuscular and oral routes.
Artesunate is water-soluble and is administered intravenously or orally. Serious adverse effects are uncommon.
Current advice for malaria in pregnancy is that the
artemisinin derivatives should be used to treat uncomplicated falciparum malaria in the second and third trimesters, but should not be prescribed in the first trimester
until more information becomes available.
Atovaquone
Atovaquone inhibits mitochondrial function. It is an oralagent, used for treatment and prophylaxis of malaria, in
combination with proguanil (see below), without which
it is ineffective. It is also employed in the treatment of
mild cases of Pneumocystis jirovecii (carinii) pneumonia,
where there is intolerance to co-trimoxazole. Significant
adverse effects are uncommon.
Folate synthesis inhibitors (proguanil, pyrimethamine–sulfadoxine)
Proguanil inhibits dihydrofolate reductase and is used
for malaria prophylaxis. Pyrimethamine–sulfadoxine is
used in the treatment of malaria.
Quinoline-containing compounds
Chloroquine and quinine are believed to act by intraparasitic inhibition of haem polymerisation, resulting in
toxic build-up of intracellular haem. The mechanisms of
action of other agents in this group (quinidine, amodiaquine, mefloquine, primaquine, etc.) may differ. They are employed in the treatment and prophylaxis of
malaria. Primaquine is used for radical cure of malaria
due to Plasmodium vivax and P. ovale (destruction of
liver hypnozoites). Chloroquine is also given for extraintestinal amoebiasis.
Chloroquine can cause a pruritus sufficient to compromise
compliance with therapy. If used in long-term,high-dose regimens, it causes an irreversible retinopathy.
Overdosage leads to life-threatening cardiotoxicity.
The side-effect profile of mefloquine includes
neuropsychiatric effects ranging from mood change,
nightmares and agitation to hallucinations and psychosis.
Quinine may cause hypoglycaemia and cardiotoxicity,
especially when administered parenterally. Primaquine causes haemolysis in people with glucose- 6-phosphate dehydrogenase deficiency which should be excluded before therapy.
Chloroquine is considered safe in pregnancy, but mefloquine should be avoided in the first trimester.
Lumefantrine
Lumefantrine is used in combination with artemetherto treat uncomplicated falciparum malaria, including
chloroquine-resistant strains. Its mechanism of action is
unknown. Significant adverse effects are uncommon.
Drugs used in trypanosomiasis
Benznidazole
Benznidazole is an oral agent used to treat South
American trypanosomiasis (Chagas’ disease).
Significant and common adverse effects include
dose-related peripheral neuropathy, purpuric rash and
granulocytopenia.
Eflornithine
Eflornithine inhibits biosynthesis of polyamines by ornithinedecarboxylase inhibition, and is used in West
African trypanosomiasis (T. brucei gambiense infection) of
the CNS. It is administered as an intravenous infusion
4 times daily, which may be logistically difficult in the
geographic areas affected by this disease. Significant
adverse effects are common, and include convulsions,
gastrointestinal upset and bone marrow depression.
Eflornithine is also used (topically) to treat hirsutism.
Melarsoprol
This is an arsenical agent, used to treat CNS infectionsin East and West African trypanosomiasis (T. brucei
rhodesiense and gambiense). It is administered intravenously.
Melarsoprol treatment is associated with
peripheral neuropathy and reactive arsenical encephalopathy (RAE), which carries a significant mortality.
Nifurtimox
Nifurtimox is administered orally to treat South American
trypanosomiasis (Chagas’ disease). Gastrointestinal
and neurological adverse effects are common.
Pentamidine isetionate
Pentamidine is an inhibitor of DNA replication used in
West African trypanosomiasis (T. brucei gambiense) and,
to a lesser extent, in visceral and cutaneous leishmaniasis.
It is also prescribed in Pneumocystis jirovecii (carinii)
pneumonia. It is administered via intravenous or intramuscular routes. It is a relatively toxic drug, commonly
causing rash, renal impairment, profound hypotension
(especially on rapid infusion), electrolyte disturbances,
blood dyscrasias and hypoglycaemia.
Suramin
Suramin is a naphthaline dye derivative, used to treatEast African trypanosomiasis (T. brucei rhodesiense).
It is administered intravenously.
Adverse effects are common, and include rash, gastrointestinal disturbance, blood dyscrasias, peripheral neuropathies and renal impairment.
Other antiprotozoal agents
Pentavalent antimonialsSodium stibogluconate and meglumine antimoniate
inhibit protozoal glycolysis by phosphofructokinase
inhibition. They are used parenterally (intravenous or
intramuscular) to treat leishmaniasis. Adverse effects
include arthralgia, myalgias, raised hepatic transaminases,
pancreatitis and ECG changes. Severe cardiotoxicity
leading to death is not uncommon.
Diloxanide furoate
This oral agent is used to eliminate luminal cysts following
treatment of intestinal amoebiasis, or in asymptomatic
cyst excreters. The drug is absorbed slowly
(enabling luminal persistence) and has no effect in
hepatic amoebiasis. It is a relatively non-toxic drug, the
most significant adverse effect being flatulence.
Iodoquinol (di-iodohydroxyquinoline)
Iodoquinol is a quinoline derivative with activityagainst Entamoeba histolytica cysts and trophozoites.
It is used orally to treat asymptomatic cyst excreters
or, in association with another amoebicide (e.g. metronidazole), to treat extra-intestinal amoebiasis.
Long-term use of this drug is not recommended, as neurological adverse effects include optic neuritis and peripheral neuropathy.
Nitazoxanide
Nitazoxanide is an inhibitor of pyruvate–ferredoxinoxidoreductase-dependent anaerobic energy metabolism
in protozoa. It is a broad-spectrum agent, active
against various nematodes, tapeworms, flukes and
intestinal protozoa. Nitazoxanide also has activity
against some anaerobic bacteria and viruses. It is
administered orally in giardiasis and cryptosporidiosis.
Adverse effects are usually mild and involve the
gastrointestinal tract (e.g. nausea, diarrhoea and abdominal pain).
Paromomycin
Paromomycin is an aminoglycoside that is used
to treat visceral leishmaniasis and intestinal amoebiasis.
It is not significantly absorbed when administered
orally, and is therefore given orally for intestinal amoebiasis and by intramuscular injection for leishmaniasis.
It showed early promise in the treatment of HIVassociated
cryptosporidiosis, but subsequent trials have
demonstrated that this effect is marginal at best.